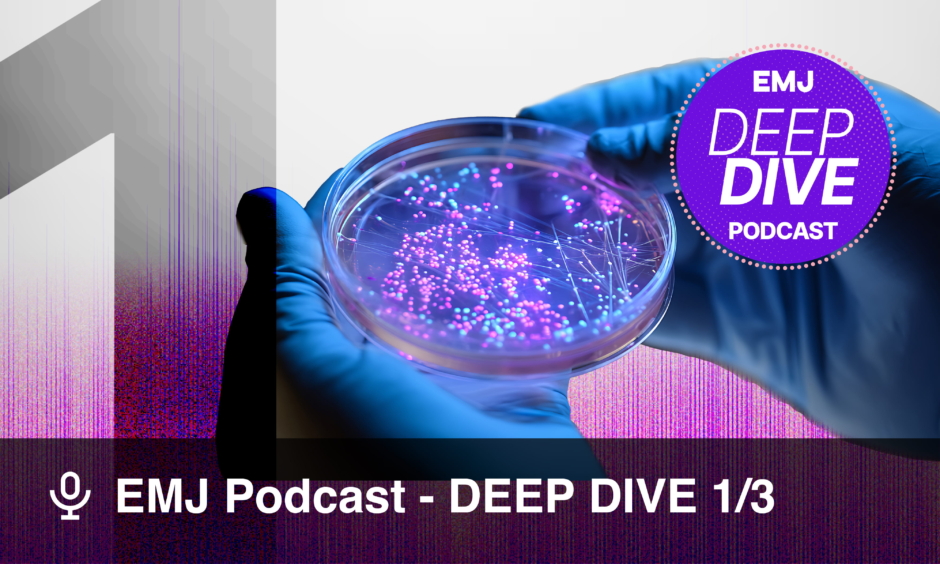

EMJ Podcast | Quickfire & Deep Dive
Why is antimicrobial resistance (AMR) one of the greatest threats to child health today? In the first instalment of our ‘Silent Pandemic’ series on AMR, host Catherine Glass speaks with Glenda Gray, paediatrician, infectious disease expert, and Chair of the Global Antibiotic Research and Development Partnership (GARDP). They explore the threat of AMR to child health, challenges in antibiotic development and access, and how lessons from HIV and vaccine research can guide a global response to protect the world’s most vulnerable children.
Speaker Bio:
Glenda Gray is Director of the Infectious Disease and Oncology Research Institute at the University of the Witwatersrand, South Africa; Chief Scientific Officer at the South African Medical Research Council (SAMRC); and Chair of the Global Antibiotic Research and Development Partnership (GARDP). A globally recognised paediatrician and public health leader, she is renowned for her pioneering work in HIV prevention, vaccine research, and maternal and child health, and now leads international efforts to address antimicrobial resistance.